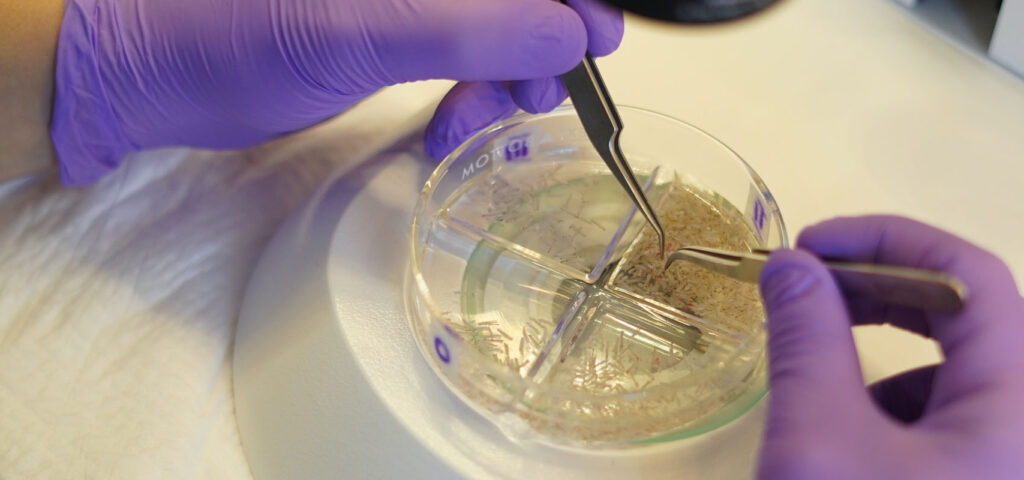
selekcja pobranych graftow selekcja pobranych graftow

Jedno z najczęstszych pytań, jakie słyszymy od Pacjentów planujących przeszczep włosów, brzmi: „Ile graftów będzie mi potrzebne?” Odpowiedź nie jest jednoznaczna, ponieważ liczba przeszczepów (graftów) zależy od wielu indywidualnych czynników, takich jak stopień łysienia, jakość włosów w strefie dawcy czy oczekiwana gęstość. W tym wpisie wyjaśniamy, jak określa się potrzebną liczbę graftów i jakie metody stosujemy w Klinice Piotra Turkowskiego, by uzyskać precyzyjny plan zabiegu.
Czym są grafty do przeszczepu włosów?
Grafty (ang. hair grafts) to podstawowe jednostki wykorzystywane w przeszczepie włosów. Każdy graft to fragment skóry głowy zawierający 1 do 4 mieszków włosowych, czyli naturalnych „korzeni” włosa. To właśnie te mieszki, a nie same włosy, są przeszczepiane podczas zabiegu.
Grafty to niewielkie fragmenty skóry głowy, które zawierają mieszki włosowe – struktury odpowiedzialne za wzrost włosów. W jednym graftcie znajduje się zazwyczaj od jednego do czterech mieszków, co oznacza, że pojedynczy graft może dawać od jednego do kilku nowych włosów po przeszczepie. W zabiegach przeszczepu włosów nie przenosi się samych włosów, lecz właśnie te grafty, dzięki czemu przeszczepione mieszki mogą produkować nowe, zdrowe włosy w miejscu, gdzie doszło do ich utraty.
Grafty pobierane są najczęściej z tzw. strefy dawcy – obszaru z tyłu i po bokach głowy, który jest genetycznie odporny na łysienie. Następnie, z dużą precyzją, wszczepia się je w miejsca objęte łysieniem, czyli w tzw. strefę biorczą. Dzięki nowoczesnym technikom, takim jak FUE (Follicular Unit Extraction), możliwe jest pobieranie pojedynczych graftów bez pozostawiania widocznych blizn, co przekłada się na bardzo naturalny i estetyczny efekt końcowy.
Grafty stanowią więc fundament całego procesu przeszczepu włosów. Ich jakość, liczba i sposób rozmieszczenia mają bezpośredni wpływ na ostateczny wygląd fryzury, gęstość włosów i trwałość efektów.
Dowiedz się więcej: Czym są grafty i jak wygląda ich pobieranie
Kiedy wskazany jest przeszczep graftów?
Przeszczep graftów wskazany jest wtedy, gdy utrata włosów jest na tyle zaawansowana, że inne metody – takie jak leczenie farmakologiczne, suplementacja czy kosmetyki zagęszczające – nie przynoszą oczekiwanych rezultatów. Najczęściej dotyczy to osób cierpiących na łysienie androgenowe, które jest uwarunkowane genetycznie i postępuje z wiekiem. W takich przypadkach przeszczep włosów staje się jedyną skuteczną i trwałą metodą przywrócenia owłosienia w miejscach, gdzie doszło do jego znacznego przerzedzenia lub całkowitej utraty.

Zabieg może być również wskazany u Pacjentów po urazach, oparzeniach czy operacjach, które pozostawiły trwałe blizny pozbawione włosów. Czasami przeszczep wykonuje się także z powodów estetycznych – np. w celu korekcji linii włosów, zakoli czy poprawy gęstości w konkretnym obszarze, takim jak korona głowy. Warunkiem przeprowadzenia zabiegu jest jednak odpowiednia ilość i jakość włosów w strefie dawcy – bez niej niemożliwe jest uzyskanie naturalnego efektu i trwałego pokrycia obszaru biorczego.
Decyzja o wykonaniu przeszczepu podejmowana jest indywidualnie, po dokładnej analizie skóry głowy, rodzaju łysienia oraz oczekiwań Pacjenta. W wielu przypadkach to właśnie konsultacja z doświadczonym specjalistą pozwala określić, czy i kiedy przeszczep graftów będzie najlepszym rozwiązaniem.
Na czym polega przeszczep graftów?
Przeszczep graftów polega na przeniesieniu mieszków włosowych z jednej części ciała – najczęściej z tyłu lub boków głowy (czyli ze strefy dawcy) – do obszarów dotkniętych łysieniem, czyli tzw. strefy biorczej. Jest to precyzyjny zabieg mikrochirurgiczny, który pozwala trwale odbudować owłosienie w miejscach, gdzie doszło do jego utraty.
Cały proces rozpoczyna się od pobrania graftów, czyli małych jednostek skóry zawierających 1–4 mieszki włosowe. W nowoczesnych metodach, takich jak FUE (Follicular Unit Extraction), każdy graft pobierany jest osobno za pomocą specjalnych mikronarzędzi, co minimalizuje uszkodzenia i eliminuje konieczność wykonywania dużych nacięć. W starszej metodzie FUT (Strip), pobierano pasek skóry, z którego następnie wyodrębniono grafty.

Po przygotowaniu strefy biorczej lekarz tworzy mikrokanaliki, w które wszczepia pobrane grafty. Ułożenie, kąt i kierunek wzrostu mieszków włosowych muszą być dopasowane do naturalnego wzoru wzrostu włosów Pacjenta, aby końcowy efekt był estetyczny i realistyczny.
Zabieg odbywa się w znieczuleniu miejscowym i nie powoduje dyskomfortu u Pacjenta. Po przeszczepie przez kilka dni widoczne są niewielkie strupki, a ostateczne efekty zaczynają być zauważalne po kilku miesiącach – kiedy przeszczepione mieszki rozpoczynają regularny cykl wzrostu nowych, trwałych włosów.
Jak lekarz wybiera liczbę graftów do przeszczepu?
Dobór liczby graftów do przeszczepu to jeden z najważniejszych etapów planowania zabiegu i zawsze odbywa się indywidualnie – na podstawie dokładnej oceny stanu włosów Pacjenta, jego oczekiwań oraz możliwości technicznych. Lekarz nie tylko określa, ile graftów będzie potrzebnych, ale także ocenia, ile można bezpiecznie pobrać ze strefy dawcy, by nie doprowadzić do jej przerzedzenia.
Proces zaczyna się od analizy stopnia łysienia, najczęściej przy użyciu skali Norwood-Hamilton (u mężczyzn) lub Ludwig (u kobiet). To pozwala zorientować się, jak rozległa jest utrata włosów i ile centymetrów kwadratowych trzeba będzie pokryć. Następnie lekarz ocenia gęstość i jakość włosów w strefie dawcy – grube, ciemne włosy dają lepsze efekty wizualne i często pozwalają użyć mniejszej liczby graftów. Istotne są także indywidualne oczekiwania Pacjenta – czy zależy mu na bardzo gęstym efekcie, czy raczej na delikatnym zakamuflowaniu przerzedzeń.
Na podstawie tych danych lekarz może obliczyć liczbę potrzebnych graftów – najczęściej według wzoru: powierzchnia obszaru biorczego (cm²) × docelowa gęstość graftów (np. 30–50/cm²). Czasem wykorzystuje się także specjalistyczne oprogramowanie lub trichoskopię, które pozwalają jeszcze precyzyjniej ocenić potrzeby i możliwości pacjenta.
Finalna decyzja to efekt połączenia danych technicznych, wiedzy medycznej i estetycznego wyczucia – wszystko po to, by efekt był jak najbardziej naturalny i trwały.
Jakie są metody przeszczepu graftów?
Istnieją dwie główne metody przeszczepu graftów, które różnią się sposobem pobierania mieszków włosowych ze strefy dawcy: FUE i FUT. Obie techniki mają swoje zalety i są dobierane indywidualnie – w zależności od oczekiwań Pacjenta, typu włosów, stanu skóry głowy oraz doświadczenia lekarza.
Metoda FUE, czyli Follicular Unit Extraction, polega na pobieraniu pojedynczych graftów – bardzo małych fragmentów skóry zawierających mieszki włosowe – za pomocą cienkiego narzędzia przypominającego mikroigłę. Ten proces nie wymaga cięcia skóry ani szwów, dzięki czemu nie pozostawia widocznych blizn. Każdy graft jest precyzyjnie usuwany z tylnej lub bocznej części głowy, a następnie przeszczepiany w miejsce, gdzie brakuje włosów. FUE jest dziś najczęściej wybieraną techniką, ponieważ zapewnia bardzo naturalny efekt i umożliwia szybki powrót do codziennych aktywności.
Zobacz więcej: Metody przeszczepu włosów: FUE, ARTAS, STRIP
Z kolei metoda FUT, znana również jako STRIP, opiera się na wycięciu cienkiego paska skóry z tyłu głowy. Z tego fragmentu wyodrębnia się pod mikroskopem pojedyncze grafty, które później przeszczepia się w obszary łysiejące. Miejsce po pobraniu paska skóry zostaje zszyte, co pozostawia cienką, liniową bliznę. Choć jest to metoda bardziej inwazyjna, nadal bywa wykorzystywana – zwłaszcza u Pacjentów z dużymi obszarami łysienia, u których potrzeba większej liczby graftów w krótszym czasie.
We współczesnych klinikach, takich jak Klinika Piotra Turkowskiego, stosuje się także innowacyjne warianty metody FUE, np. zabieg z użyciem ostrzy z szafiru (Sapphire FUE) czy technikę DHI, która pozwala na natychmiastowe wszczepienie graftów bez wcześniejszego tworzenia nacięć. Dzięki temu cały proces jest jeszcze bardziej precyzyjny, a rekonwalescencja – krótsza i mniej uciążliwa.
Wybór odpowiedniej metody zawsze poprzedzony jest szczegółową konsultacją. To właśnie podczas niej lekarz ocenia stan skóry głowy, jakość włosów i oczekiwania Pacjenta, by zaproponować rozwiązanie najlepiej dopasowane do indywidualnych potrzeb.